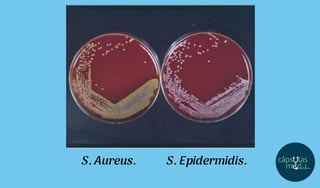
S. Aureus. S. Epidermidis.
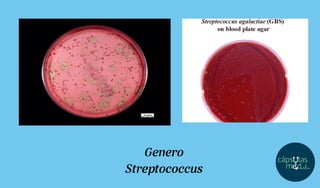
Genero
Streptococcus
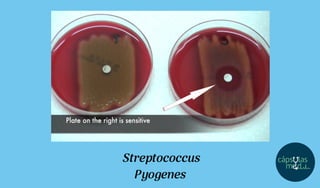
Streptococcus
Pyogenes
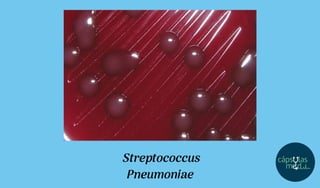
Streptococcus
Pneumoniae
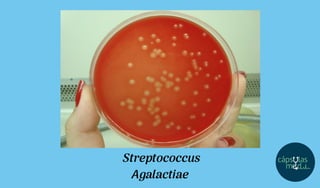
Streptococcus
Agalactiae
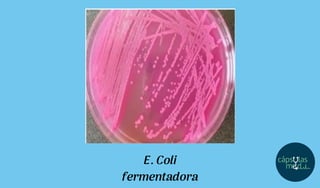
E. Coli
fermentadora
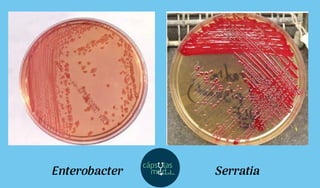
Enterobacter Serratia
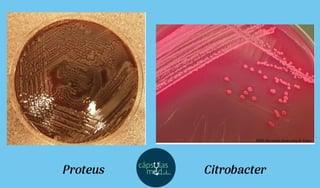
Proteus Citrobacter
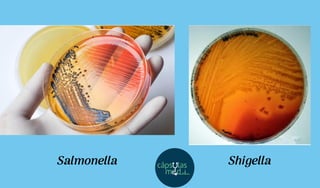
Salmonella Shigella
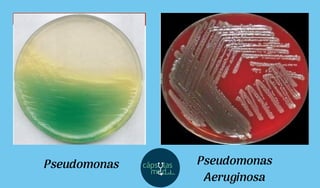
Pseudomonas Pseudomonas
Aeruginosa
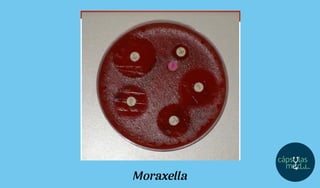
Moraxella

El documento presenta una serie de tarjetas didácticas sobre microbiología, enfocadas en características y diagnóstico de bacterias gram positivas y negativas, así como su relevancia clínica. Incluye detalles sobre la tinción de Gram, la morfología, patogenicidad y enfermedades asociadas a diversos géneros bacterianos. Además, se proporcionan métodos de diagnóstico y tratamiento para infecciones causadas por estas bacterias.